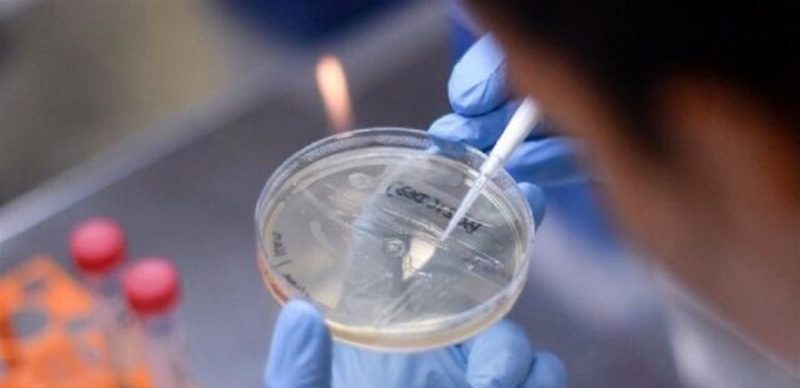

أظهرت بيانات مركز السيطرة على الأمراض الأميركي (CDC)، ارتفاع حالات الإصابة بعدوى “نوروفيروس” المصنف كأكثر الأسباب شيوعا لالتهاب المعدة والأمعاء الحاد، في الولايات المتحدة.
وذكرت شبكة “سي إن إن” الأميركية أن حالات الإصابة بـ”نوروفيروس” في الولايات المتحدة تتصاعد على قدم المساواة مع الاتجاهات الموسمية، وفقًا لأحدث البيانات الصادرة عن المراكز الأميركية لمكافحة الأمراض والوقاية منها.
ويعد “نوروفيروس”، السبب الأكثر شيوعا لالتهاب المعدة والأمعاء الحاد في الولايات المتحدة، فهو يسبب ما بين 19 مليونا إو21 مليون مرض كل عام، غالبا في البيئات المزدحمة مثل دور رعاية المسنين ومراكز الرعاية النهارية والسفن السياحية.
وأظهرت بيانات مركز السيطرة على الأمراض، أنه في الأسبوع الماضي، جاءت أكثر من 12 بالمئة من اختبارات “نوروفيروس” إيجابية. وهذا ارتفاع من 11.5 بالمئة في الأسبوع السابق.
وترتفع الحالات بشكل خاص في الشمال الشرقي من الولايات المتحدة، حيث جاءت أكثر من 13 بالمئة من الاختبارات إيجابية. وارتفعت معدلات الإيجابية في المنطقة إلى أكثر من 13 بالمئة منذ أواخر كانون الثاني/ يناير.
ويعد تفشي “نوروفيروس” أكثر شيوعا في أواخر الخريف والشتاء وأوائل الربيع. ومن الممكن أن ينتشر عندما التلامس بشكل مباشر مع شخص مصاب، أو استهلاك طعام أو سوائل ملوثة بالفيروس.
ويحذر مركز السيطرة على الأمراض، من أن الشخص المصاب لا يزال بإمكانه نشر فيروس “نوروفيروس” بعد أسبوعين أو أكثر من اختفاء الأعراض.
ومن أعراض، الإسهال والقيء والغثيان وآلام المعدة، ولا يوجد علاج محدد لـ”نوروفيروس”، لكن الخبراء ينصحون بشرب الكثير من السوائل لتجنب الجفاف.
وفي كانون الثاني/ يناير الماضي، أصدرت إدارة الغذاء والدواء الأميركية تحذيراً من بيع واستهلاك بعض المحار من كاليفورنيا والمكسيك بسبب احتمال تلوثه بـ”نوروفيروس”.
وفي كانون الأول/ ديسمبر الماضي، تم ربط أكثر من 200 حالة يشتبه في إصابتها بـ”نوروفيروس” بمطعم سوشي في ولاية كارولاينا الشمالية.